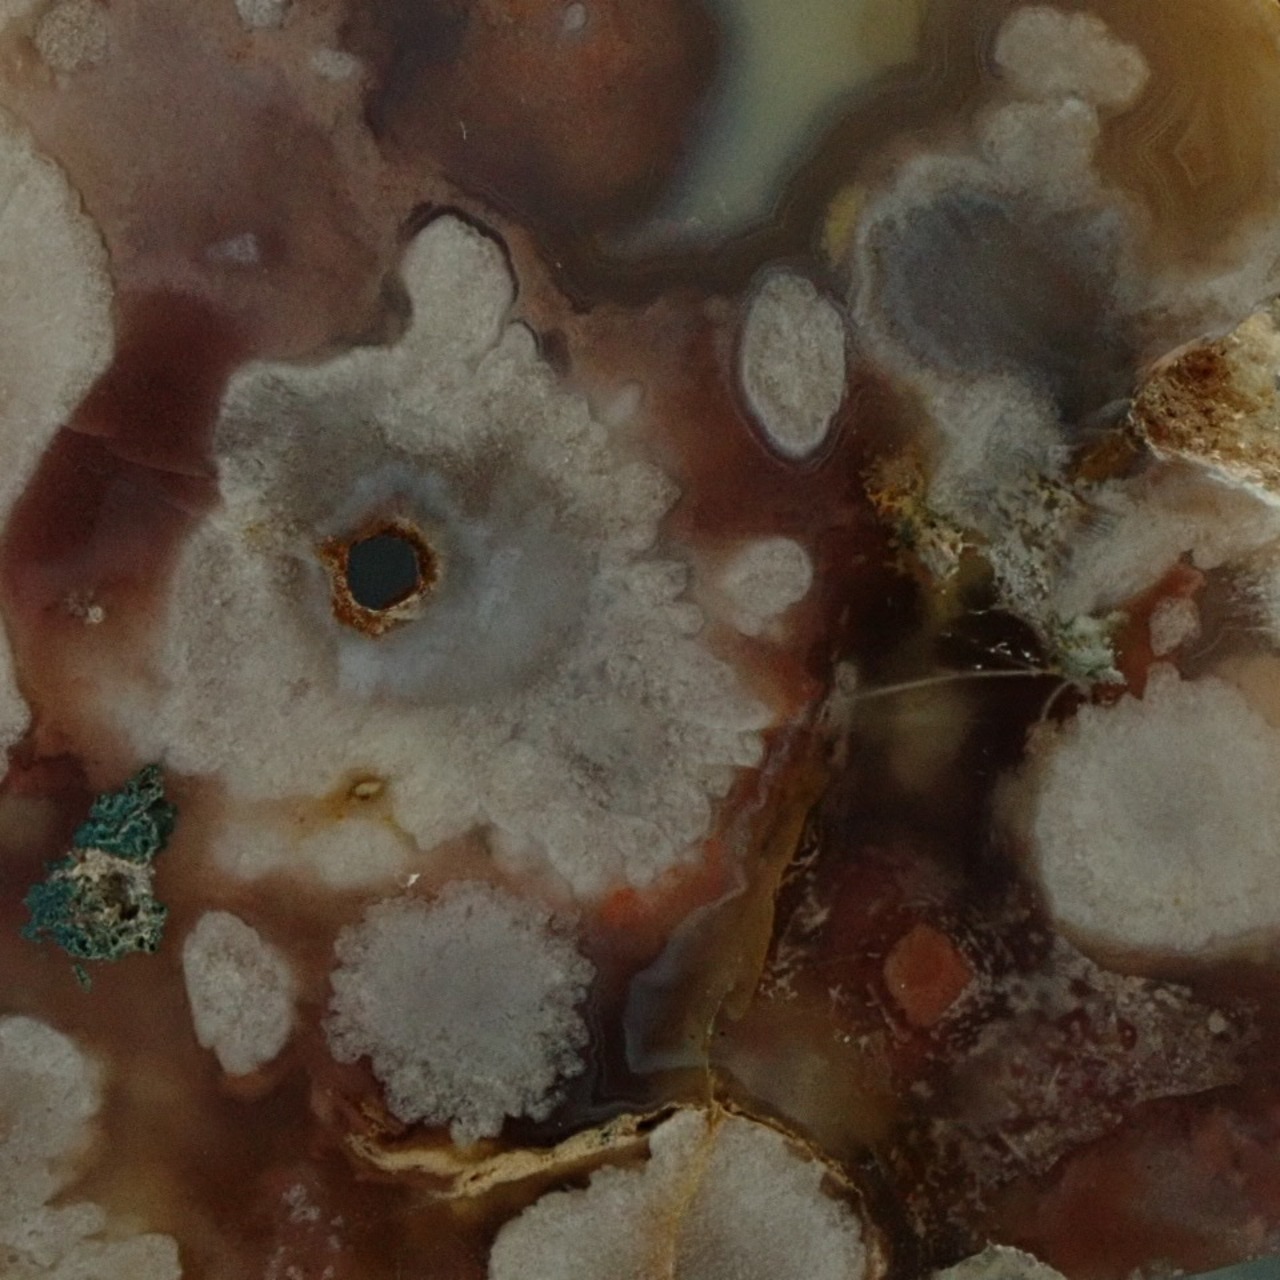

桜瑪瑙 86.8g サイズ約74mm×54mm×16mm SBA616 チェリーブロッサム アゲート サクラ メノウ
¥3,500 税込
残り1点
別途送料がかかります。送料を確認する
¥15,000以上のご注文で国内送料が無料になります。
その色、模様が、桜を連想させるからか、
チェリーブロッサムアゲート、桜瑪瑙と呼ばれ親しまれています。
厚みのあるスライス瑪瑙で、
一般的なスライス瑪瑙の3枚分はあり、存在感があります。
アゲート/瑪瑙は非常に細かい石英が、
綿密に集合し結晶したものです。
アゲートの名の由来は、
イタリアのシチリア島から多く発見され、
そこにある古い川の名前であるアカテスからアケート、
そこからさらに「Agate」になったと言われ、
和名である瑪瑙は、その産状が腎臓状で馬の脳だったことが、
その由来で命名されたと言われます。
アゲートにまつわる伝承として、
様々な国、民族により多種多様な使われ方をし、
装飾品、手紙、記録の封印の印章等が使用例にあります。
日本では、江戸時代に火打石などにも使われました。
現在でも、ある外国の紳士靴ブランドで扱われる
最高級本革コードバンの凹凸表面をならす際に、
磨いた瑪瑙、カルセドニー、アゲートが使用されています。
パワーストーンの言い伝えは、
心の安定と静寂。仕事、家庭、友人の対人関係改善。
健康、富、長寿等。コミュニケーションに関する伝承が多くあります。
※5cm角のアクリルプレート上で撮影。
大きさ比較の参考にしていただきますようお願い申し上げます。
※ご購入前に必ず「About」をお読みください。
発送・商品等に関しての重要な事項が記載されています。
-
レビュー
(411)
-
送料・配送方法について
-
お支払い方法について
¥3,500 税込